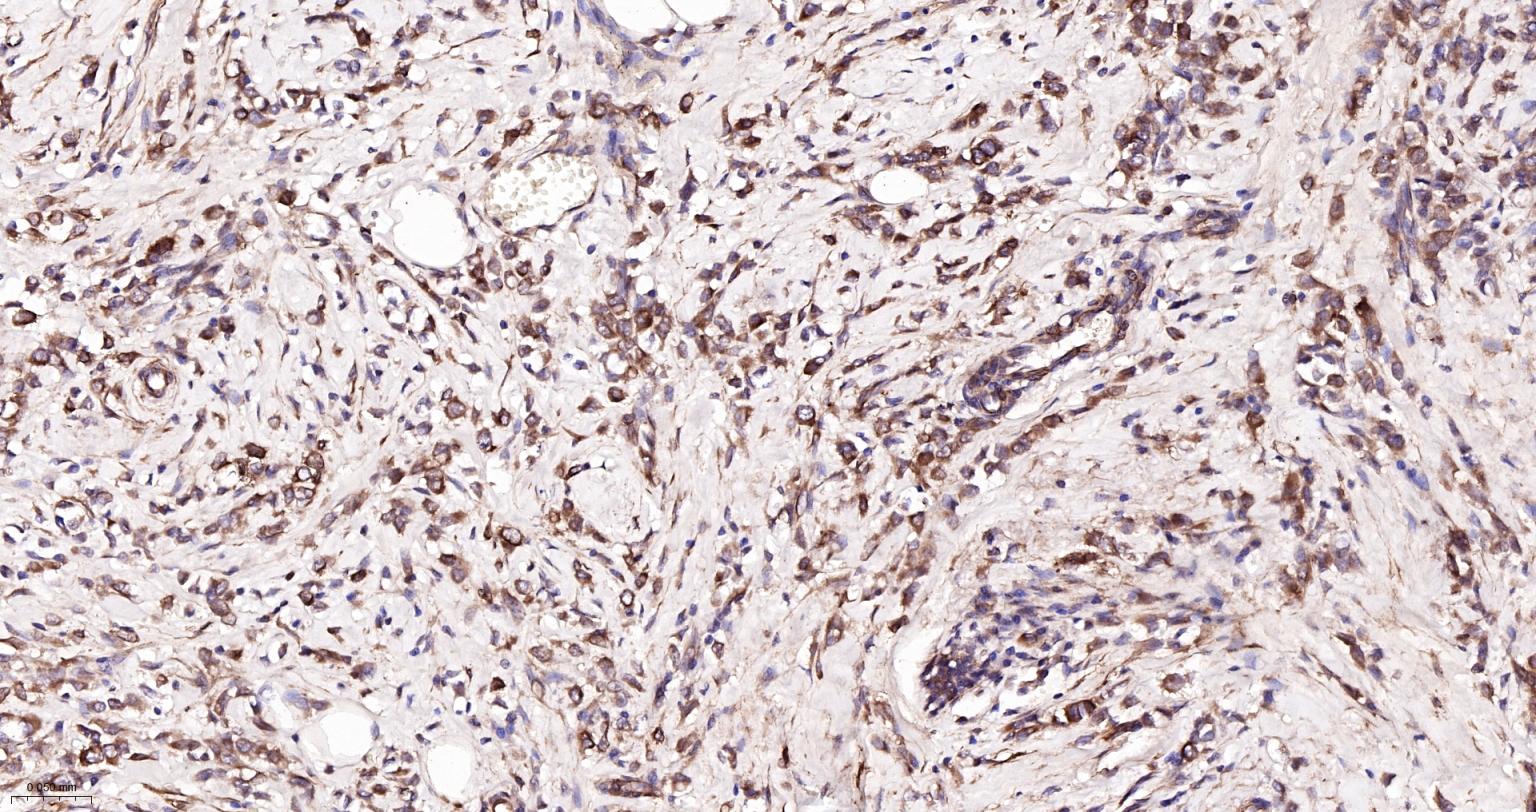
微管蛋白α/Tubulin α/α-tubulin单克隆抗体

微管蛋白α/Tubulin α/α-tubulin单克隆抗体

货号:bsm-33039M
产品详情
相关标记
相关产品
相关文献
常见问题
概述
产品编号
bsm-33039M
产品类型
宠物抗体、模式动物抗体、农牧业/家禽抗体
英文名称
alpha Tubulin Mouse mAb
中文名称
微管蛋白α/Tubulin α/α-tubulin单克隆抗体
英文别名
B-ALPHA-1; LIS3; TUBA3; Tuba-1; Tuba1; TBA1A_HUMAN; TUBA1A; Alpha-tubulin 3; Tubulin B-alpha-1; Tubulin alpha-3 chain; 3.6.5.-; TBA1A_MOUSE; Alpha-tubulin 1; Alpha-tubulin isotype M-alpha-1; Tubulin alpha-1 chain; TBA1A_RAT;
抗体来源
Mouse
免疫原
Recombinant human alpha Tubulin Protein
亚型
IgG
性状
Size : 50ul/100ul/200ul
Liquid
Size : 200ug (PBS only)
Lyophilized
Note: Centrifuge tubes before opening. Reconstitute the lyophilized product in distilled water. Optimal concentration should be determined by the end user.
Liquid
Size : 200ug (PBS only)
Lyophilized
Note: Centrifuge tubes before opening. Reconstitute the lyophilized product in distilled water. Optimal concentration should be determined by the end user.
纯化方法
affinity purified by Protein G
克隆类型
Monoclonal
克隆号
10F11
理论分子量
50 kDa
浓度
1mg/ml
储存液
Size : 50ul/100ul/200ul
0.01M TBS (pH7.4) with 1% BSA, 0.02% Proclin300 and 50% Glycerol.
Size : 200ug (PBS only)
0.01M PBS
0.01M TBS (pH7.4) with 1% BSA, 0.02% Proclin300 and 50% Glycerol.
Size : 200ug (PBS only)
0.01M PBS
SWISS
Gene ID
保存条件
Shipped at 4℃. Store at -20℃ for one year. Avoid repeated freeze/thaw cycles.
注意事项
This product as supplied is intended for research use only, not for use in human, therapeutic or diagnostic applications.
数据库链接
产品介绍
结构蛋白(Structural Proteins)
tubulin是一种大量存在于哺乳动物脑组织中的微管亚基蛋白,在结构上是由两个极为相近的α和β亚基组成的二聚体、多聚体形成微管细丝,是微管的主要成分。
微管蛋白是球形分子, 有两种类型:α微管蛋白(α-tubulin)和β微管蛋白(β-tubulin)货号:bs-0210R, 这两种微管蛋白具有相似的三维结构, 能够紧密地结合成二聚体, 作为微管组装的亚基。
α亚基由450个氨基酸组成, β亚基是由455个氨基酸组成, 这两种亚基有35~40%的氨基酸序列同源, 表明编码它们的基因可能是由同一原始祖先演变而来.
tubulin是一种大量存在于哺乳动物脑组织中的微管亚基蛋白,在结构上是由两个极为相近的α和β亚基组成的二聚体、多聚体形成微管细丝,是微管的主要成分。
微管蛋白是球形分子, 有两种类型:α微管蛋白(α-tubulin)和β微管蛋白(β-tubulin)货号:bs-0210R, 这两种微管蛋白具有相似的三维结构, 能够紧密地结合成二聚体, 作为微管组装的亚基。
α亚基由450个氨基酸组成, β亚基是由455个氨基酸组成, 这两种亚基有35~40%的氨基酸序列同源, 表明编码它们的基因可能是由同一原始祖先演变而来.
背景资料
bs-0159P is one synthetic peptide derived from human Tubulin-alpha 1.
Tubulin is a major cytoskeleton that has five distinct forms, designated alpha, beta, gamma, delta and epsilon tubulin. The alpha and beta tubulins form a heterodimer that polymerize into the cylindrical microtubule fibers. Both alpha and beta tubulin bind GTP. Only beta tubulin hydrolyzes GTP to GDP. This hydrolysis is a process that is linked to tubulin polymerization and microtubule formation. The alpha tubulin isomer can be modified by addition of a C-terminal tyrosine residue. This modification may influence polymerization rates. The gamma tubulin isomer is localized to centrosomes which compose the heart of the microtubule organizing center from which microtubule fibers emanate.
Tubulin is a major cytoskeleton that has five distinct forms, designated alpha, beta, gamma, delta and epsilon tubulin. The alpha and beta tubulins form a heterodimer that polymerize into the cylindrical microtubule fibers. Both alpha and beta tubulin bind GTP. Only beta tubulin hydrolyzes GTP to GDP. This hydrolysis is a process that is linked to tubulin polymerization and microtubule formation. The alpha tubulin isomer can be modified by addition of a C-terminal tyrosine residue. This modification may influence polymerization rates. The gamma tubulin isomer is localized to centrosomes which compose the heart of the microtubule organizing center from which microtubule fibers emanate.

产品应用
| 应用 | 已检合格种属 | 预测种属 | 推荐稀释比例 |
|---|---|---|---|
| WB | Human, Mouse, Rat | Rabbit, Pig, Zebrafish, Chicken, Dog, GuineaPig | 1:5000-100000 |
| IHC-P | Human, Mouse, Rat | Rabbit, Pig, Zebrafish, Chicken, Dog, GuineaPig | 1:500-1000 |
| IHC-F | Human, Mouse, Rat | Rabbit, Pig, Zebrafish, Chicken, Dog, GuineaPig | 1:500-1000 |
| IF | Human, Mouse, Rat | Rabbit, Pig, Zebrafish, Chicken, Dog, GuineaPig | 1:500-1000 |
| Flow-Cyt | Human | Mouse, Rat, Rabbit, Pig, Zebrafish, Chicken, Dog, GuineaPig | 1:50-100 |
| ICC/IF | Human | Mouse, Rat, Rabbit, Pig, Zebrafish, Chicken, Dog, GuineaPig | 1:50-200 |
交叉反应
交叉反应: Human, Mouse, Rat (predicted: Rabbit, Pig, Zebrafish, Chicken, Dog, GuineaPig)
相关产品
暂无相关产品
靶标
基因名
TUBA1A
蛋白名
Tubulin alpha-1A chain
亚基
Dimer of alpha and beta chains.
亚细胞定位
Cytoplasm, cytoskeleton.
组织特异性
Ubiquitously expressed with highest levels in Brain, Bone, Adipocyte, and Breast
翻译后修饰
Some glutamate residues at the C-terminus are polyglutamylated. This modification occurs exclusively on glutamate residues and results in polyglutamate chains on the gamma-carboxyl group. Also monoglycylated but not polyglycylated due to the absence of functional TTLL10 in human. Monoglycylation is mainly limited to tubulin incorporated into axonemes (cilia and flagella) whereas glutamylation is prevalent in neuronal cells, centrioles, axonemes, and the mitotic spindle. Both modifications can coexist on the same protein on adjacent residues, and lowering glycylation levels increases polyglutamylation, and reciprocally. The precise function of such modifications is still unclear but they regulate the assembly and dynamics of axonemal microtubules (Probable).
Acetylation of alpha chains at Lys-40 stabilizes microtubules and affects affinity and processivity of microtubule motors. This modification has a role in multiple cellular functions, ranging from cell motility, cell cycle progression or cell differentiation to intracellular trafficking and signaling.
Acetylation of alpha chains at Lys-40 stabilizes microtubules and affects affinity and processivity of microtubule motors. This modification has a role in multiple cellular functions, ranging from cell motility, cell cycle progression or cell differentiation to intracellular trafficking and signaling.
相似性
Belongs to the tubulin family.
功能
Tubulin is the major constituent of microtubules. It binds two moles of GTP, one at an exchangeable site on the beta chain and one at a non-exchangeable site on the alpha chain.
标记抗体
暂无标记数据
同靶标产品
暂无同靶标产品
相关文献
提示: 发表研究结果有使用 bsm-33039M 时请让我们知道,以便我们可以引用参考文章。作为回馈,资料提供者将获得我们送上的小礼品。
具体参考文献:bsm-33039M 被引用于9文献中
暂无相关文献
常见问题
暂无常见问题